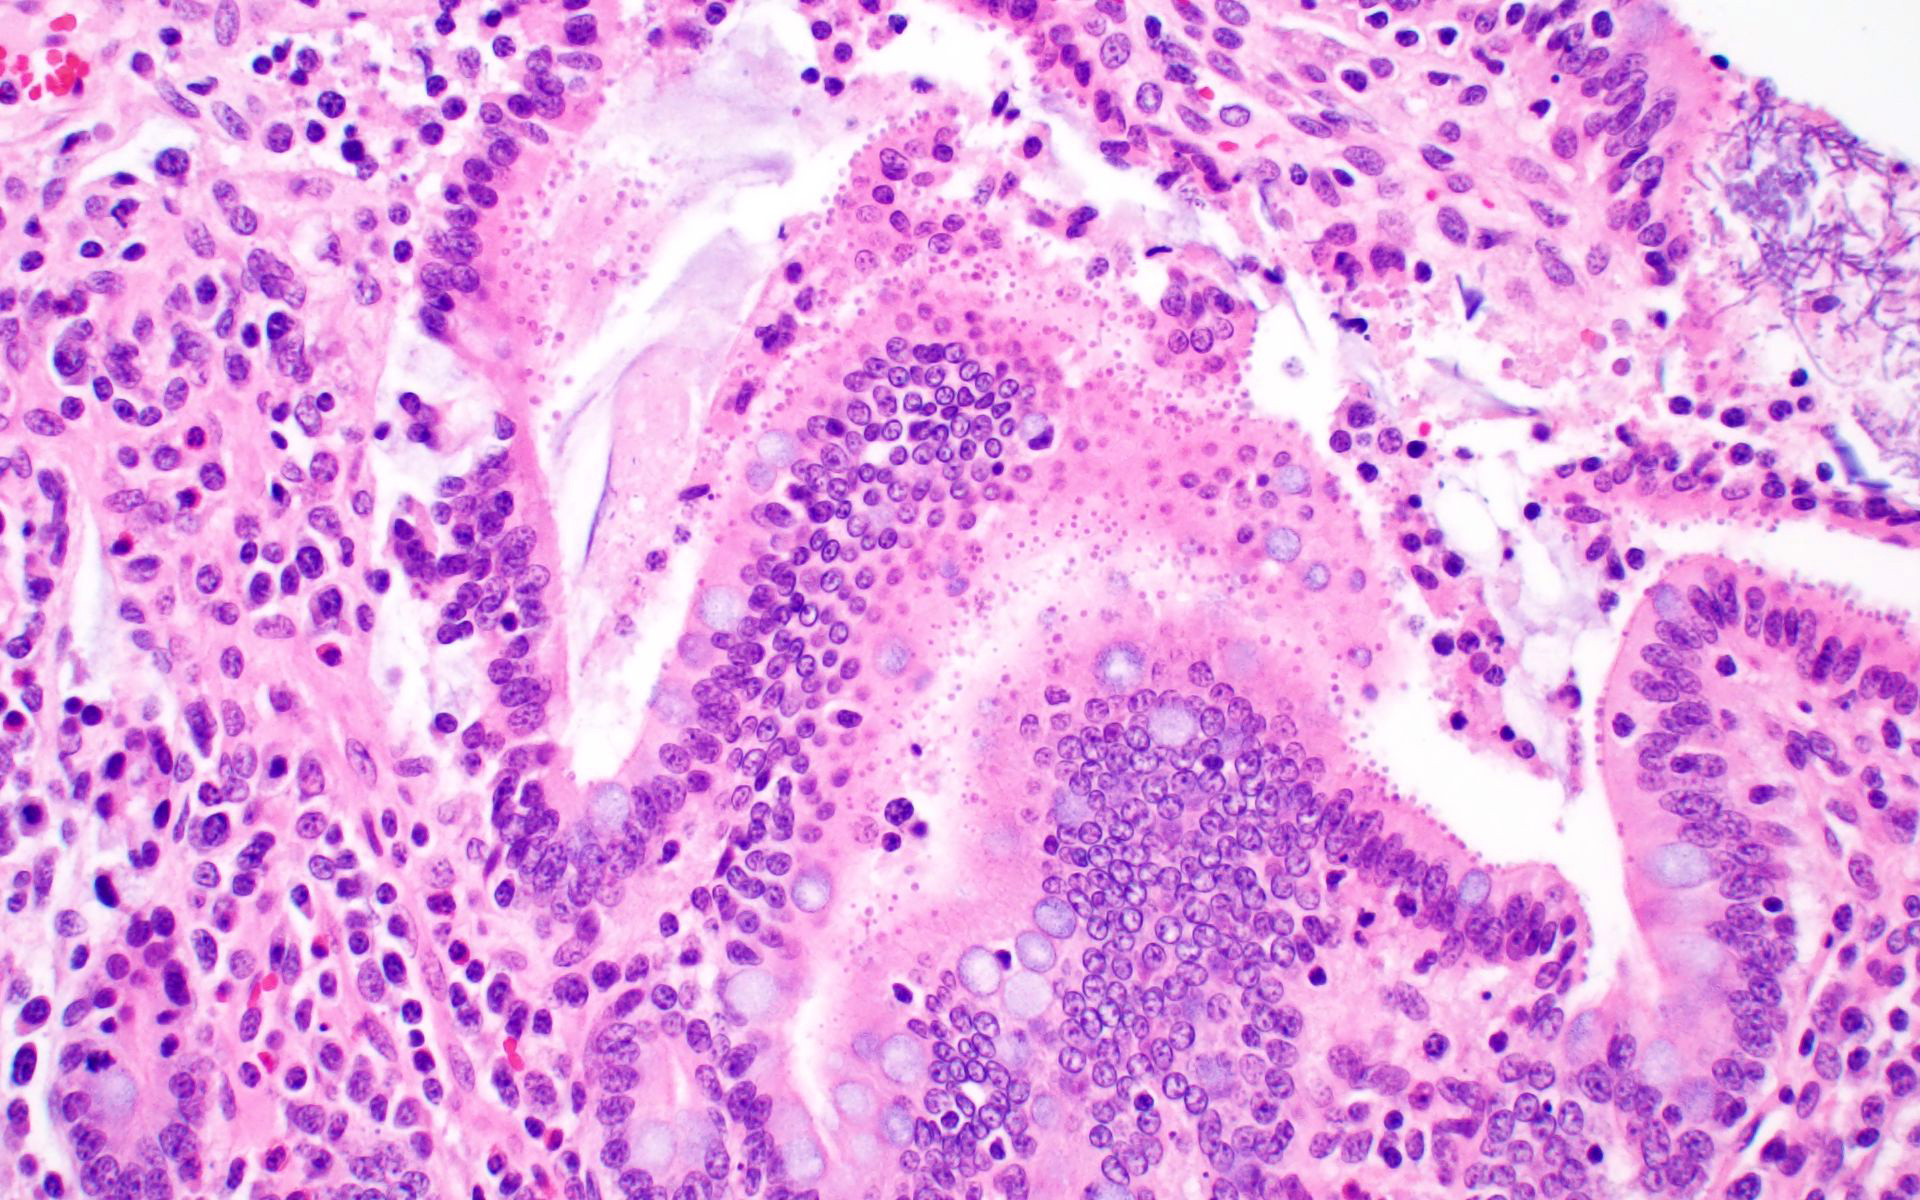
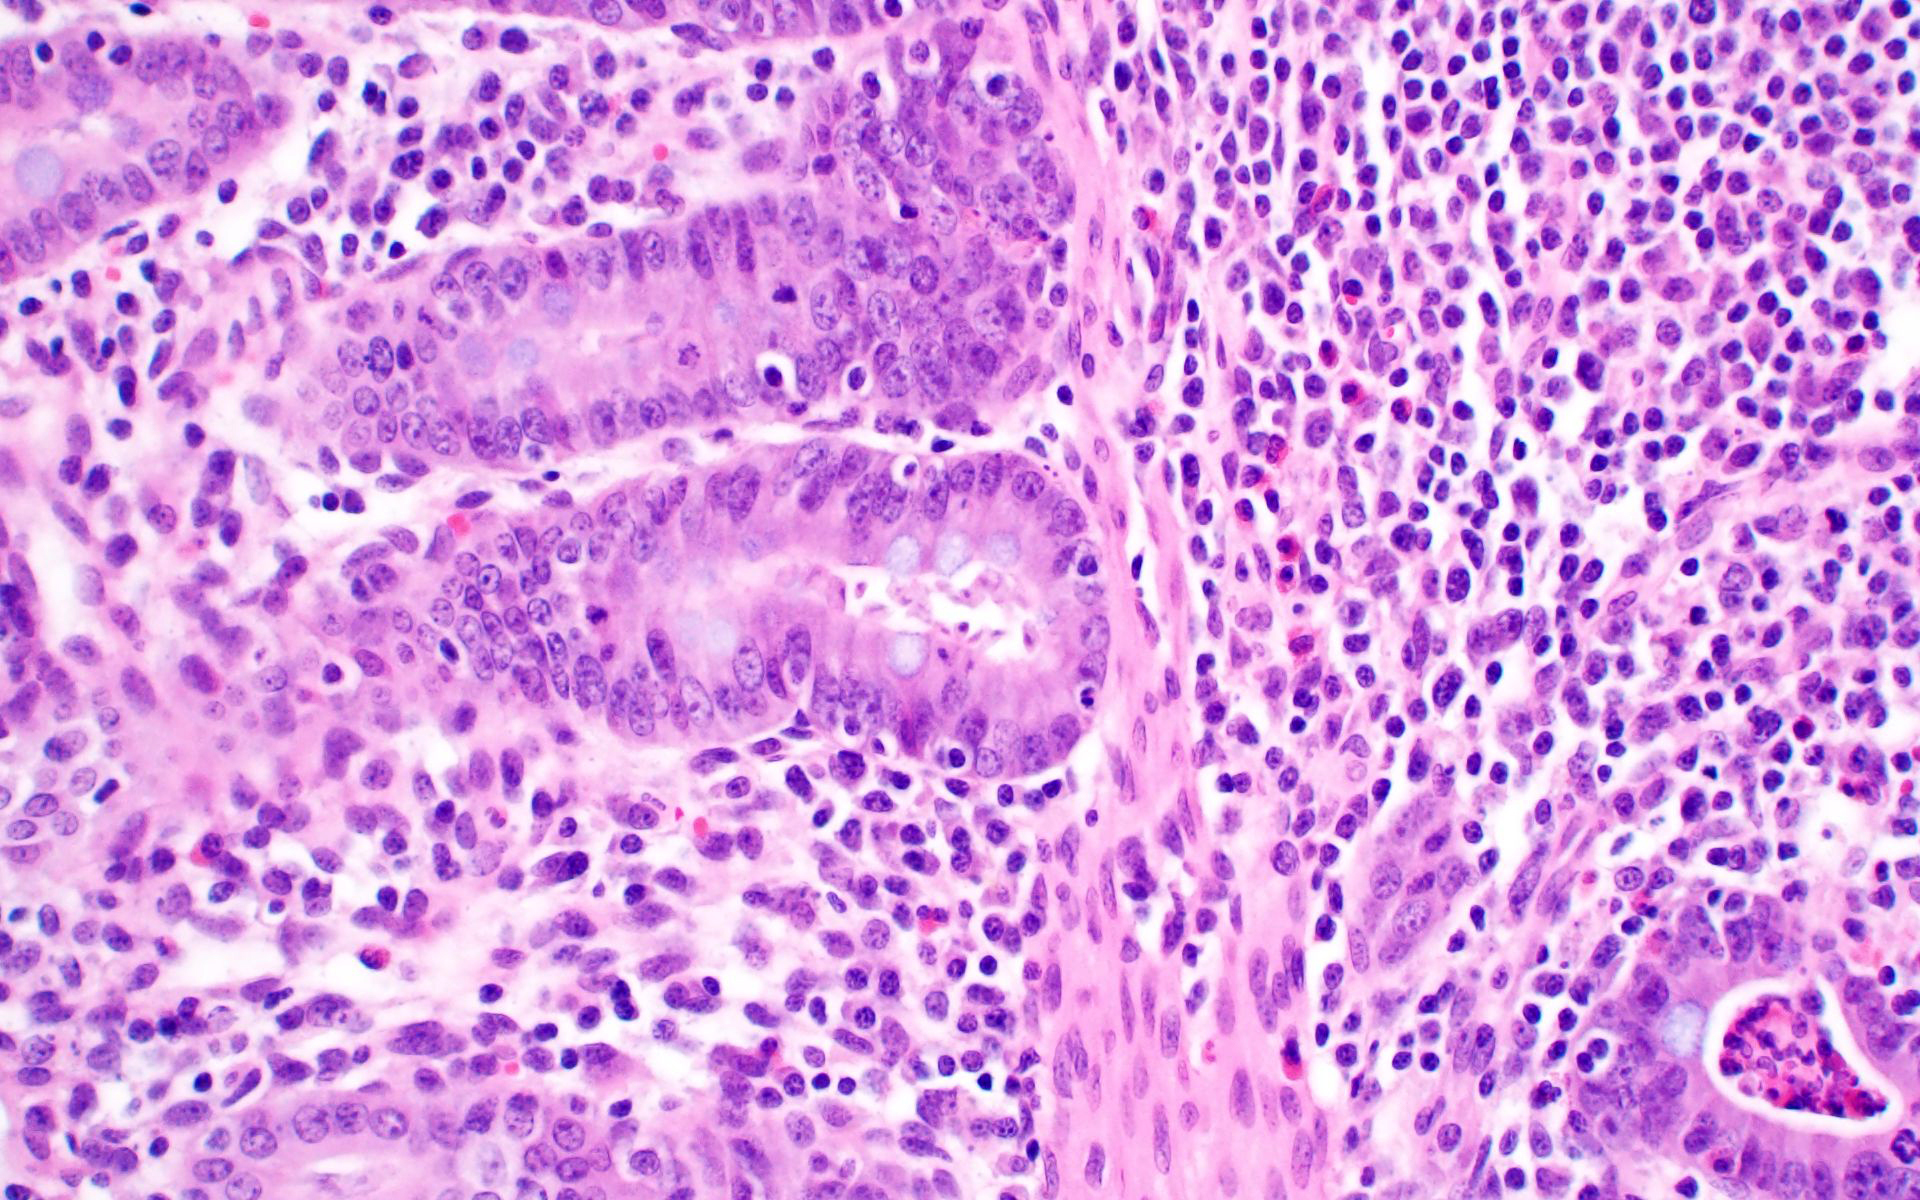

Wednesday Slide Conference, 2025-2026, Conference 7, Case 2
Signalment:
Three-week-old castrated male PIC Camborough ® x PIC 800 ® cross bred pig (Sus scrofa).History:
Gross Pathology: This pig exhibited significant ataxia and paresis, and would “high-step” if made to walk. It would often become laterally recumbent but typically stayed centrally aware. Eye movement was normal. The piglet was thin and gaunt, with a raised coarse hair coat. All lung lobes were diffusely tan, rubbery, and non-collapsing with multifocal lobules in the cranial and middle lung lobes that were diffusely dark red and firm. Colon content was green-brown and watery, but the associated tissue was grossly unremarkable. The stomach of this animal was full of feed, and no ulcers were apparent. Tracheobronchial and ileac lymph nodes were enlarged.Laboratory Results:
- PRRSV PCR (lung): Positive (Ct = 11.1)
- IAV PCR (lung): Negative
- PCV 2/3 Differential PCR (spleen): Negative
- TGEV/PEDV/PDCoV Differential PCR: Negative
- PRRSV IHC (intestine/colon): Abundant strong punctate intracytoplasmic staining in mononuclear cells with morphology similar to macrophages in the mediastinal lymph node, Peyer’s patches, and lamina propria.
- Bacterial culture: Low growth from both the intestine and colon of Salmonella enterica ssp enterica serovar Heidelberg.
Microscopic Description:
Ileum: In several sections, there is moderate multifocal blunting and fusion of villi with a crypt: villus ratio of 1:1. Apical enterocytes are often moderately attenuated with loss of the brush border and reduced apical cytoplasm. In some sections, these cells have a profound number of intracellular but extracytoplasmic 1-2 um circular eosinophilic apicomplexan organisms with 0.5 um basophilic nuclei (Cryptosporidium sp.). In other sections, these cells contain numerous larger apicomplexans with varied life-stages apparent including: 10 x 5 um curvilinear binucleate meronts (type I meronts), 4 x 12 um curvilinear uninucleate merozoites (type I merozoites), 9 x 6 um ovoid multinucleate meronts (type II meronts), multiple 3 x 12 um curvilinear uninucleate merozoites joined at their base by a residual body (type II merozoites), a 12um diameter circular lightly basophilic microgamont filled with numerous peripheral uninucleate deeply basophilic microgametes, or a 18 um diameter circular lightly basophilic macrogamont with a 8 um granular circular nucleus (macrogamont) (Cystoisospora suis). Rare crypts are ectatic, lined by moderately flattened, attenuated epithelium, and filled with cellular and karyorrhectic debris admixed with rare degenerate neutrophils (crypt abscesses). The associated lamina propria is often infiltrated by numerous eosinophils admixed with a few neutrophils. In one section, there is profound necrosis in Peyer’s patches, characterized by abundant karyorrhectic and cellular debris admixed with rare neutrophils, that often obscures typical follicular architecture. Similar changes are occasionally present in the overlying lamina propria, with marked lymphocytolysis and loss of proprial architecture. Vascular structures in all tunics are moderately congested, and macrophages occasionally aggregate around medium-caliber vessels in the submucosa.Spiral Colon: In both sections, there is moderate multifocal ulceration of the colonic mucosa characterized by loss of apical colonocytes with abundant cellular and karyorrhectic debris admixed with minimal fibrin and extravasated erythrocytes adhered to the exposed lamina propria. Adjacent colonocytes are often flattened, irregularly spaced, with reduced apical cytoplasm (attenuation). The associated lamina propria is often infiltrated by neutrophils and eosinophils admixed with necrotic debris and a few macrophages. Crypts within these areas are often ectatic, lined by mildly attenuated epithelium, and filled with either cellular and karyorrhectic debris admixed with degenerate neutrophils (crypt abscesses) or numerous eosinophils. Several other crypts are filled with up to 15 5 x 7 um pyriform to crescent-shaped protozoa with lightly basophilic cytoplasm and a faint nucleus (Suspect Trichomonads). The colonic lumen contains abundant cellular debris admixed with numerous colonies of basophilic bacteria with morphology ranging from coccoid to bacillary to filamentous, as well as rare 80 um circular flagellated protozoa with a prominent bean-shaped nucleus and a large cytoplasmic vacuole and abundant phagocytosed cellular debris (Suspect Balantidium coli). The submucosa is multifocally infiltrated by numerous macrophages admixed with lymphocytes and a small amount of karyorrhectic debris and these cells often aggregate around medium to large caliber vessels. Multifocally the cortical and medullary architecture of the mesenteric lymph node is effaced by abundant cellular and karyorrhectic debris (lymphocytolysis) admixed with rare infiltrating neutrophils and macrophages.
Contributor's Morphologic Diagnoses:
Ileum and colon (mediastinal lymph node, Peyer’s patches, and lamina propria): Lymphoid necrosis, multifocal, profound, subacute.Ileum: Atrophic enteritis, necrosuppurative and eosinophilic segmental, marked, subacute, with crypt abscesses and numerous intralesional apicomplexans with morphology consistent with Cryptosporidium spp. and Cystoisospora suis
Colon: Ulcerative colitis, segmental, marked, subacute, with crypt abscesses and numerous intralesional protozoans with morphology consistent with Balantidium coli, and Trichomonads.
Contributor's Comment:
This is great example of a real-world production animal diagnostic case. It’s also a great reminder to look for a primary etiology when there are multiple organisms/changes present in a piece of tissue that aren’t typically seen together. Cryptosporidium suis and scrofarum are present in many commercial pigs but typically do not cause clinical disease and are generally not histologically apparent.8,13 The presence of such profound quantities of Cryptosporidium spp. in this case suggests primary immune suppression. The larger apicomplexan present in this slide has life stages that are morphologically consistent with Cystoisospora suis. While this organism can act as a primary enteric pathogen in pigs, it is also present at low levels in many commercial swine post-weaning without causing clinical disease, often with few if any histologically apparent life-stages. The presence of both types of meronts, both types of merozoites, as well as microgamonts and macrogamonts in a single section of tissue is unusual and also suggests that primary immune suppression may be at play. Lindsay et al. did a great job describing these life stages in a in 1980 Journal of Parasitology paper.7 The moderate ulcerative colitis in this animal is typical of a Salmonella spp. It’s also common to have Balantidium coli find their way into these colonic lesions, often phagocytosing necrotic debris.9,13 The pyriform organisms in the colonic crypts are morphologically consistent with trichomonads. Tetratrichomanas foetus, suis,buttreyi, and Pentatrichomonas hominis have all been described as inhabitants of the porcine digestive tract. Others are likely present in pigs, and there have been increased efforts, especially in China, to better characterize these organisms.6 They are commonly seen in higher numbers in porcine colonic crypts during disease or dysbiosis.PCV-2 parasitizes lymphocytes and is a common cause of immune suppression in commercial pigs. However, this virus typically causes lymphoid depletion with granulomatous inflammation and rarely intracytoplasmic botryoid inclusion bodies. PCV-2/3 differential PCR was negative in this animal. The massive amount of karyorrhectic debris in the lymphoid tissue is more in line with PRRSV infection, which was detected at a very low CT in lung, and colocalized to the lesioned enteric lymphoid tissue by IHC. PRRSV is a member of the family Arteriviridae, which together with Coronaviridae, Roniviridae, and Mesonoviridae form the order Nidovirales, a contemporarily relevant viral order that has evolved a unique replication strategy utilizing discontinuous extension and a set of nested subgenomic mRNAs. The economic impact of PRRSV in the US is estimated to be $660 million annually, and a reasonable case could be made that this is the most economically important virus of any domestic species in the US.3 PRRSV replicates in macrophages and, to a lesser extent, dendritic cells. There was much historical controversy about the receptor utilized by this virus for cell entry. In a landmark paper, Prather et al. were able to demonstrate complete resistance to the virus by knocking out CD163 in commercial pigs with CRISPR/Cas9 methods.11 CD163 (HbSR) is a hemoglobin scavenger receptor that is expressed in cells of the monocyte-macrophage lineage.1 Currently, CD163 knock-out pigs are working their way through the federal regulatory system, with the genetics company involved hoping to market a completely PRRSV resistant animal. This may have huge economic implications given the limited success of commercial vaccines against this phylogenetically diverse virus. While this virus is classically associated with interstitial pneumonia with intralesional “necrotic macrophages”, it’s a systemic pathogen that can infect macrophages in any body system, especially lymphoid tissue. The terms “necrotic macrophages” and “lymphoid necrosis” are somewhat controversial in PRRSV infection. An early paper utilizing tunnel assays, demonstrated widespread apoptosis of noninfected cells in the lung, testes, and lymphoid tissue, giving rise to the idea of “bystander-apoptosis” involvement in the pathogenesis of this virus.10 Subsequent papers further characterizing the involvement of intrinsic/extrinsic/other apoptotic pathways in infected and uninfected cells are conflicting.2 At the very least it can be stated that much of the cell death in a PRRSV infection occurs in uninfected cells, and a significant proportion of those cells are likely apoptotic as opposed to necrotic.
PRRSV-associated lesions and IHC staining were also present in the lung, brain, spleen, and tracheobronchial lymph nodes of this animal (not included on this slide).
In this case, the clinical signs in the population are not the result of a lateral introduction of any of the 4 protozoans described or the Salmonella sp. isolated. Rather, all of these organisms were endemic in this population and caused no clinically apparent disease. The introduction of a new PRRSV strain into the sow farm resulted in significant immune suppression in weaned pigs, disrupting the balance of the enteric ecosystem, culminating in enhanced replication of Cryptosporidium spp, Cystoisospora suis and several trichomonads.
Contributing Institution:
Department of Veterinary Pathology, College of Veterinary medicine, Iowa State University, 1800 Christensen Drive, Ames, Iowa 50011-1134 https://vetmed.iastate.edu/vpathJPC Diagnoses:
- Ileal Peyer’s patches and mesenteric lymph nodes: Lymphoid depletion, chronic, diffuse, marked, with lymphocytolysis.
- Ileum: Villar blunting, diffuse, marked with numerous intracytoplasmic, extracellular apicomplexan schizonts and gamonts consistent with Cryptosporidium sp., and intracytoplasmic, intracellular apicomplexan meronts, schizonts, and gamonts consistent with coccidiosis.
- Colon: Colitis, ulcerative, multifocal, mild to moderate with crypt abscesses and intraglandular flagellates.
JPC Comment:
The good folks at Iowa State provide a great write-up that touches on some very diagnostically relevant topics and stimulated excellent pathogenesis discussion during conference. The #1 take-home lesson in this case for participants was, “Don’t stop looking just because you found one cause” – a common diagnostic pitfall referred to as “search satisfaction”. As in this case, there were many, many organisms present in far greater numbers than normal as a result of virally-induced immune suppression.If you see infectious agents, think about how that organism interacts with the host animal. Then, think about if that organism should or should not be present and, if they are expected, are they present in expected numbers? If there are multiple species of agent, and they are in higher numbers than expected, a primary immune suppression should rise to the top of the list. In this case, Cryptosporidium spp, Balantidium coli, and trichomonads are found in many commercial pigs and do not typically cause disease. Cystoisospora suis can be a primary enteric pathogen of swine but may also be present in low levels in post-weaning commercial pigs without issue. However, the presence of both types of meronts, both types of merozoites, and both micro- and macrogamonts in one tissue section should raise red flags and make the pathologist look for an underlying cause that might explain the lack of immune regulation of commensals.
Other honorable mentions discussed in conference included the other members of the porcine respiratory disease complex, which are PRRSV, PCV2, Pasteurella multocida, swine influenza A, and Mycoplasma hyopneumoniae, and a quick mention of other relevant arteriviruses within veterinary species, such as equine Arterivirus (equine viral arteritis), Simian hemorrhagic fever virus in non-human primates, and lactate dehydrogenase-elevating virus in mice (although this one is pretty laid back, all things considered).
This case provides an excellent opportunity to review relevant general pathology of viral infections. One of the most critical players in innate viral defense is type I interferon (IFN-I). The initiation of IFN-I production is dependent on host pathogen recognition receptors (PRRs) that recognize pathogen-associated molecular patterns (PAMPs), which is where the whole process starts. The body must be able to recognize the “bad guy” before it can mount an appropriate response to handle it.
Certain classes of PRRs, such as the membrane-bound Toll-like receptors (TLR), specifically TLR3, TLR7/8 and TLR9, detect viral PAMPs and foreign nucleic acids within cellular endosomes and help upregulate the production of IFN-1 and pro-inflammatory cytokines. Once one of these endosomal TLRs has bound and recognized a viral PAMP, the TLR recruits the adaptor molecule TIR-containing adaptor-inducing IFN-β (TRIF). TRIF then binds Tumor Necrosis Factor Receptor Associated Factor 6 (TRAF6) and activates transforming growth factor β (TGF-β)-activated kinase-1 (TAK1) and TAK1-binding proteins (TABs).4,5 This complicated cascade results in the phosphorylation of NF-κB essential modulator (NEMO) and the activation of an IKK complex. IκBα, which is bound to and inhibits the transcription factor NF-κB, is phosphorylated and degraded by the proteosome. Upon release from its inhibitor, NF-κB translocates to the nucleus and upregulates the expression of IFN-β and inflammatory cytokines.4,5,12
Working in concert with the TLRs are cytoplasmic RIG-I-like receptors (RLRs), another class of PRR that includes retinoic acid-induced gene I (RIG-I) and melanoma differentiation associated gene 5 (MDA5), among others.4,5 These RLRs recognize viral nucleic acid in the cytosol of the affected cell. RIG-I and MDA5 both have a neat feature called the “caspase activation and recruitment domain” (CARD) which, upon activation, interacts with virus-induced signaling adaptor (VISA), the primary (and necessary) signaling adapter protein of the cytosolic RLRs.4,5,12 These interactions allow RLRs to relocate to mitochondrial membranes and initiate the formation of the VISA signalosome, which basically functions as a scaffold to which other proteins can stick.4 The assembled VISA signalosome recruits TNF receptor-associated factors (TRAFs) or Fas-associated death domain protein (FADD), which activate caspases 8 and 10.4,5 These caspases then stimulate NF-κB activation. Once activated, NF-κB translocates to the nucleus to its job of upregulating production of IFN-1 and other cytokines as described above.
Now the body has IFN-1 circulating about. Now what? IFN-I binds to its receptor, appropriately named type I IFN receptor, and initiates the Janus kinase signal transducer and activator of transcription (JAK-STAT) pathway, thereby resulting in the expression of numerous IFN-1 stimulated genes that ultimately rev up the anti-viral adaptive immune response.4,5 Several arteriviruses, including PRRSV, cleave signaling molecules of IFN-I responses.4 A recent study demonstrated that highly pathogenic PRRSV and its nsp4 protein antagonize IFN-1 expression by cleaving VISA and NEMO to block NF-κB signaling pathways.4 Cue some commentary about evolution being an arms race…
PRRSV infection occurs primarily through alveolar macrophages in the lung of infected pigs. On top of its anti-IFN-1 actions, PRRSV primarily utilizes a CD163 receptor, especially the scavenger receptor cysteine-rich domain 5 (SRCR5) of the receptor, to infect macrophages.1,2,5 The interaction between the PRRSV minor envelope glycoproteins (GP2a and GP4) and the CD163 SRCR5 domain facilitates the release of genetic material from the virus, thereby enabling viral replication within the infected cell.1,2,5
As mentioned by the contributor in their excellent write-up, targeting this interaction by blocking viral binding or removing CD163 from the cell surface is a promising strategy for controlling PRRSV. Currently, ABS, one of the premier genetics companies for livestock, is developing a CD163-knockout pig strain that is resistant to PRRSV.11 Long story short, no receptor for PRRSV to bind = no PRRSV infection. This has massive implications for both commercial pig operations and research labs. Research is generally reliant upon smaller, younger pigs. PRRSV has been a challenging confounder of research findings in these pigs, as they are transported in from commercial farms and can develop respiratory disease secondary to transport stress. If a pig has PRRSV and is then utilized for a study, who’s to say what lesions are due to PRRSV and what lesions are due to the agent of study interest? Although many institutes are actively looking to reduce the use of animals, some studies are still reliant upon live animal models. Being able to utilize PRRSV-resistant pigs could be a huge leap forward for such studies and would very likely reduce the overall number of animals needed for study completion.
References:
- Etzerodt A. and Moestrup SK. CD163 and inflammation: biological, diagnostic, and therapeutic aspects.Antioxid Redox Signal. 2013. 18(17):2352-63.
- Fan L. Signaling pathways involved in regulating apoptosis induction in host cells upon PRRSV infection.Virus Genes. 2019. 55(4):433-439.
- Holtkamp DJ, et al. Assessment of the economic impact of porcine reproductive and respiratory syndrome virus on United States pork producers.Journal of Swine Health and Production. 2013. 21(2):72-84.
- Huang C, Du Y, Yu Z, Zhang Q, Liu Y, Tang J, Shi J, and Feng W. Highly pathogenic porcine reproductive and respiratory syndrome virus nsp4 cleaves VISA to impair antiviral responses mediated by RIG-1-like receptors. Scientific Reports. 2016;6(1):28497.
- Huang C, Zhang Q, Guo XK, Yu ZB, Xu AT, Tang J, Feng WH. Porcine reproductive and respiratory syndrome virus nonstructural protein 4 antagonizes beta interferon expression by targeting the NF-κB essential modulator. J Virol. 2014;88(18):10934-45.
- Li W, et al., The prevalence of intestinal trichomonads in Chinese pigs.Veterinary Parasitology. 2015. 211(1):12-15.
- Lindsay, DS, et al. Endogenous development of the swine coccidium, Isospora suis Biester 1934. J Parasitol. 1980. 66(5):771-9.
- Pettersson E, et al. Detection and molecular characterisation of Cryptosporidium spp. in Swedish pigs.Acta Veterinaria Scandinavica. 2020. 62(1):40.
- Schuster FL and Ramirez-Avila L. Current world status of Balantidium coli.Clin Microbiol Rev. 21(4):626-38.
- Sur JH, Doster AR, and Osorio FA. Apoptosis induced in vivo during acute infection by porcine reproductive and respiratory syndrome virus. Vet Pathol. 1998. 35(6):506-14.
- Whitworth, KM, et al. Gene-edited pigs are protected from porcine reproductive and respiratory syndrome virus.Nature Biotechnology. 2016. 34(1):20-22.
- Xu LG, Wang YY, Han KJ, Li LY, Zhai Z, Shu HB. VISA is an adapter protein required for virus-triggered IFN-beta signaling. Mol Cell. 2005;19(6):727-40.
- Zimmerman JJ. Diseases of Swine. 11th edition. ed. 2019. Hoboken, NJ: Wiley-Blackwell.